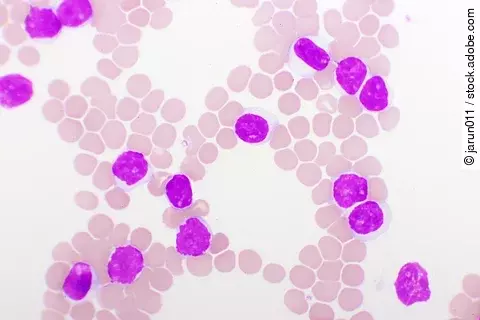
Blutbild bei chronischer lymphatischer Leukämie (CLL), mikroskopisch analysiert, Originalvergrößerung 1000-fach

Kongressberichte
Mit freundlicher Unterstützung von hematooncology.com
ASH-Kongress 2025 in OrlandoInnovative Zell- und Antikörpertherapien definieren Behandlungsstandards beim multiplen Myelom neu
Mit freundlicher Unterstützung von hematooncology.com